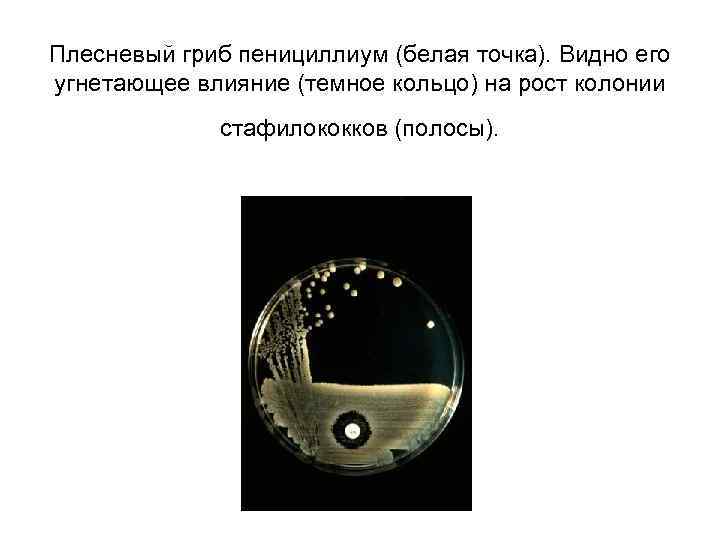
Плесневый гриб пенициллиум (белая точка). Видно его угнетающее влияние (темное кольцо) на рост колонии

Lektsia11-_AntibakterPr-ty_ispravl.ppt
- Количество слайдов: 63

АНТИБАКТЕРИАЛЬНЫЕ ЛЕКАРСТВЕННЫЕ СРЕДСТВА


Антибиотики • Термин “антибиотики” ввел в обращение американский микробиолог З. Ваксман, получивший в 1952 году Нобелевскую премию за открытие стрептомицина. • Ваксман предложил называть все вещества, вырабатываемые микроорганизмами для уничтожения или нарушения развития других микроорганизмов-противников, антибиотиками. • Сам же термин антибиос (“анти” – против, “биос” – жизнь), отражающий форму сосуществования микроорганизмов в природе, когда один организм убивает или подавляет развитие “противника” путем выработки особых веществ, был придуман Л. Пастером, вложившим в него определенный смысл – “жизнь – против жизни”

Антибиотики • В борьбе за существование микроорганизмы создали и усовершенствовали оружие, которое позволяет им отстаивать свою среду обитания. • Это оружие – специальные вещества, названные антибиотиками. Они безвредны для хозяина, но смертельно опасны для его врагов – других микроорганизмов. • С их помощью микроорганизмы успешно защищают, а при случае и расширяют “свои территории”.

Антибиотики • Изобретение антибиотиков можно назвать революцией в медицине. Множество болезней, веками мучавших человечество и несших смерть, стали банальными, как обычная простуда. • Считается, что открытие антибиотиков прибавило примерно 20 лет к средней продолжительности жизни человека в развитых странах. • Микробиолог Зинаида Ермольева, получившая в 1942 году первые в СССР образцы пенициллина, объясняла значение антибиотиков так: “Если бы в XIX веке был пенициллин, Пушкин бы не умер от раны”.

История создания антибиотиков • Первый антибиотик – пенициллин – был выделен из плесневого гриба Penicillium notatum, чему и обязан своим названием. • За его создание в 1945 году три ученых: Флеминг, Флори и Чейн были удостоены Нобелевской премии. • В 20 -х годах в одной из лондонских больниц работал Александр Флеминг. Однажды Флеминг обнаружил, что плесень, случайно попавшая на поверхность среды с культурой стрептококка, как бы растворила ее. Стало очевидным, что плесень вырабатывает какое-то удивительное вещество, с огромной силой действующее на бактерий.
Плесневый гриб пенициллиум (белая точка). Видно его угнетающее влияние (темное кольцо) на рост колонии стафилококков (полосы).

История создания антибиотиков • Это гипотетическое вещество Флеминг назвал пенициллином (от латинского penicillium – плесень). • Дальнейшая разработка пенициллина была связана с работой, так называемой Оксфордской группы, во главе которой стояли Говард Флори и Эрнст Чейн занимался выделением пенициллина, а Флори – испытанием его на животных. • В результате был получен малотоксичный и эффективный пенициллин. 12 февраля 1941 года пенициллин был впервые применен для лечения человека. Первым пациентом оказался лондонский полицейский, умиравший от заражения крови. После нескольких инъекций ему стало лучше, через день он уже ел без посторонней помощи. Но запас с таким трудом полученного пенициллина закончился, и больной скончался.

История создания антибиотиков • Промышленный выпуск препарата был налажен только в 1943 году в США, куда Флори передал технологию получения нового лекарства. Причем американский штамм (подвид) плесени был найден на одной из гнилых дынь, выброшенных на помойку. • В нашей стране пенициллин создали в 1942 году два биолога З. В. Ермольева и Т. И. Балезина с сотрудниками. В одном из московских подвалов они обнаружили штамм пенициллиум крустозум, который оказался продуктивнее английских и американских родичей.

История создания антибиотиков • Это отметил и Флори, приезжавший в январе 1944 года в СССР с американским штаммом. Он был удивлен и восхищен тем, что у нас есть более продуктивный штамм и уже налажено промышленное производство пенициллина. • После того, как была доказана возможность получения антибиотиков из микроорганизмов, открытие новых препаратов стало вопросом времени - в 1939 году был выделен грамицидин, в 1942 – стрептомицин, в 1945 – хлортетрациклин, в 1947 – левомицетин (хлорамфеникол), а уже к 1950 году было описано более 100 антибиотиков

Избирательность действия • Под избирательным действием понимают активность только в отношении возбудителей инфекции, при сохранении жизнеспособности клеток хозяина, и действие не на все, а на определенные роды и виды микроорганизмов. • Следует отличать антибиотики от антисептиков, которые действуют на микроорганизмы неизбирательно и применяются для уничтожения возбудителей на поверхности кожи и слизистых, а также дезинфектантов, предназначенных для неизбирательного уничтожения микроорганизмов на объектах внешней среды.

Классификация антибактериальных лекарственных средств • • АНТИБИОТКИ СУЛЬФАНИЛАМИДЫ ФТОРХИНОЛОНЫ НИТРОФУРАНЫ • Примечание: Формально под термином «антибиотики» понимают только те вещества, которые вырабатываются микробами. Следовательно, такие антибактериальные или противомикробные средства, как сульфаниламиды, фторхинолоны и нитрофураны, строго говоря, не антибиотики. Но в Европе их часто объединяют одним термином антибиотики

Классификация антибиотиков по химическому структуре 1. β – лактамы 1. 1. пенициллины 1. 2. цефалоспорины 2. Аминогликозиды 3. Тетрациклины 4. Макролиды 5. Линкозамиды 6. Амфениколы 7. Полимиксины 8. Римфамицины 9. Полиены

Классификация антибактериальных препаратов по происхождению • Природные (собственно антибиотики, например, пенициллин, полимиксин, тиамулин). • Полусинтетические (продукты модификации природных молекул: амоксициллин, цефтиофур, тилмикозин). • Синтетические (хлорамфеникол, сульфаниламиды, фторхинолоны, нитрофураны).

Классификация по спектру активности в отношении микроорганизмов Препараты широкого спектра действия • Тетрациклины и хлорамфеникол (грамположительные и грамотрицательные микроорганизмы, микоплазмы, некоторые виды риккетсий и простейших) • Аминогликозиды, цефалоспорины, ампициллин, амоксициллин (грамположительные и грамотрицательные микроорганизмы) • Нитрофураны, сульфаниламиды, фторхинолоны (грамположительные и грамотрицательные микроорганизмы, некоторые виды вирусов и простейших) Препараты узкого спектра действия • Бензилпенициллин, метициллин, оксациллин, фузидин, рифампицин (грамположительные микроорганизмы) • Макролиды, линкомицин, тилозин (грамположительные микроорганизмы, микоплазмы) • Полимиксин (грамотрицательные микроорганизмы), полиеновые антибиотики (грибы), метронидазол, нитазол (простейшие)

Классификация по типу действия на микробную клетку Бактерицидный Бактериостатический • Пенициллины • Тетрациклины Цефалоспорины Макролиды Аминогликозиды Хлорамфеникол Полимиксин Сульфаниламиды Фторхинолоны Нитазол, метронидазол Нитрофураны (в низкой высокой концентрации)

Классификация антибиотиков по механизму действия на микробную клетку • Ингибиторы синтеза клеточной стенки микроорганизма: пенициллины, цефалоспорины, бацитрацин. • Нарушающие молекулярную организацию и функции клеточных мембран: полимиксин, нистатин, леворин, амфотерицин; • Подавляющие синтез белка и нуклеиновых кислот: а) ингибиторы синтеза белка на уровне рибосом: хлорамфеникол, тетрациклины, макролиды, линкомицин, клиндамицин, аминогликозиды, фузидин; б) ингибиторы РНК-полимеразы (рифампицин) и ДНК-гиразы (фторхинолоны)

Структура клеточной стенки бактерий • Важная особенность бактериальной клетки, отличающая ее от клеток млекопитающих, - прочная клеточная стенка, окружающая цитоплазматическую мембрану. Эта стенка предохраняет бактериальную клетку от действия осмотического давления, которое в ней приблизительно на 20 атм выше, чем в жидкостях макроорганизма. • Прочность клеточной стенке придает пептидогликан (муреин), который образует жесткий каркас вокруг бактериальной клетки, поддерживая ее форму, и защищает клетку от разрушения внутренним осмотическим давлением. • Образование поперечных сшивок между молекулами пептидогликана обеспечивают два фермента – транспептидаза и карбоксипептидаза.

Структура клеточной стенки бактерий • У грамположительных бактерий стенка имеет толщину 20 -80 нм и представляет собой единственную структуру, окружающую снаружи цитоплазматическую мембрану, содержит до 50% пептидогликана. • У грамотрицательных бактерий клеточная стенка намного тоньше (1 нм) и покрыта наружной липопротеиновой мембраной, содержит до 10% пептидогликана.

А – клеточная стенка грамположительных микроорганизмов Б – клеточная стенка грамотрицательных микроорганизмов

Механизм действия антибиотиков основанный на нарушении синтеза клеточной стенки 1. 2. 3. 4. β -лактамные антибиотики (пенициллины) связываются с ферментами – транспептидазой и карбоксипептидазой (которые иногда называют пенициллинсвязывающие белки). Под действием пенициллина происходит инактивация (разрушение) транспептидазы и карбоксипептидазы, в результате чего молекулы пептидогликана перестают связываться между собой. Этот процесс приводит к нарушению синтеза клеточной стенки микроорганизма. Под действием внутреннего осмотического давления клеточная стенка разрывается и микроорганизм погибает.

Механизм действия природных β-лактамных антибиотиков • • • Пенициллины активны в отношении грамположительных микроорганизмов, т. к. в их клеточной стенке много пептидогликана (до 50%). Пенициллины слабо активны в отношении грамотрицательных микроорганизмов, т. к. в их клеточной стенке мало пептидогликана (до 10%) и сверху клеточная стенка покрыта липопротеиновой мембраной непроницаемой для природных пенициллинов Пенициллины не активны в отношении грамположительных микоплазм, т. к. в их клеточной стенке нет пептидогликана.

Ингибирование синтеза клеточной стенки

Механизм действия антибиотиков основанный на повреждении цитоплазматической мембраны бактерий • Наиболее важные препараты из этой группы- полиеновые противогрибковые антибиотики – амфотерицин, нистатин, леворин. • Механизм их действия основан на связывании основного липида клеточной стенки гриба – эргостерола. В результате в клеточной стенке образуются поры, через которые выходят наружу необходимые для жизнедеятельности гриба полезные вещества – ионы К, ферменты, что приводит к гибели гриба. • Действие на грибы полиеновых антибиотиков довольно селективно (специфично) , т. к. в организме млекопитающих основным липидом клеточной стенки является не эргостерол, а холестерол, с которым эти антибиотики не связываются.

Повреждение цитоплазматической мембраны

Механизм действия антибиотиков основанный на ингибировании синтеза белка и нуклеиновых кислот • Избирательность действия антибиотиков этой группы на бактериальную клетку обеспечивается существенным различием рибосом у бактерий и млекопитающих. • Частицы бактериальных рибосом, обозначаемые по коэффициенту седиментации как 50 S- и 30 Sчастицы, отличаются по способности связываться с антибиотиками от частиц рибосом млекопитающих (60 S- и 40 S-).

Механизм действия антибиотиков основанный на ингибировании синтеза белка и нуклеиновых кислот • Тетрациклины соединяются с 30 S-частицей и ингибируют связывание аминоацил-т. РНК с рибосомами, угнетая начальную стадию белкового синтеза. • Аминогликозиды повышают сродство аминоацилт. РНК к определенному участку рибосом, что ведет к возникновению ошибок при считывании генетической информации и синтезу неактивных молекул белка. • Макролиды, связываясь с 50 S-частицей, ингибируют процесс переноса полипептидной цепи на аминоацил -т. РНК, а также перемещение пептидил-т. РНК к месту синтеза белка. В результате тормозится формирование полипептидной цепи.

Ингибирование синтеза белка

Уникальные особенности антибактериальных препаратов • 1. В отличие от большинства других ЛС, мишень (рецептор) антибактериальных препаратов находится не в тканях животного или человека, а в клетке микроорганизма. • 2. Активность антибактериальных препаратов не является постоянной, а снижается со временем, что обусловлено формированием лекарственной устойчивости (резистентности).

Уникальные особенности антибактериальных препаратов Резистентность – неизбежное биологическое явление и предотвратить ее практически невозможно. • 3. Резистентные возбудители представляют опасность не только для пациента, у которого они были выделены, но и для многих других животных и людей, даже разделенных временем и пространством. Поэтому борьба с лекарственной устойчивостью в настоящее время приобрела глобальные масштабы.

Резистентность микроорганизмов • Микробы, обладая очень хорошей приспособляемостью к быстро меняющимся условиям окружающей среды, “привыкают” к антибиотикам, т. е. становятся нечувствительными к нему. • В основе этого явления, известного как устойчивость, или резистентность, возбудителей заболеваний, лежит естественный отбор. • Когда бактерии сталкиваются с антибиотиком, они проходят через «сито селекции» : все бактерии, чувствительные к антибиотику, погибают, а те немногочисленные, которые в результате естественных мутаций оказались к нему невосприимчивы, выживают.

Резистентность микроорганизмов • Эти резистентные бактерии начинают стремительно размножаться на территории, освободившейся в результате гибели конкурентов. Так возникает резистентная популяция микроорганизмов (штамм). • Резистентные бактерии быстро захватывают как отдельный организм, так и целое хозяйство, целые районы, и даже “путешествуют” из одной части света в другую, что становится серьезной проблемой химиотерапии, так как появление устойчивых видов приводит к неэффективности лечения инфекционных болезней. • Устойчивые штаммы появляются тем чаще, чем длительнее применяется препарат.

Резистентность микроорганизмов • Резистентность может быть природной и приобретенной. • О природной резистентности говорят при отсутствии у микроорганизма мишени для действия антибиотика или недоступности этой мишени. • Например, b-лактамные антибиотики для реализации антибактериального эффекта связываются с ферментами транс- и карбоксипептидазами, локализованными в стенках бактериальных клеток. • Эти ферменты, отсутствуют у микоплазм, лишенных клеточных стенок. Поэтому Mycoplasma spp. обладает природной устойчивостью к b-лактамам. • Клеточная стенка большинства грамотрицательных бактерий непроницаема для макролидов. Указанные микроорганизмы также обладают природной устойчивостью к этому классу антибиотиков.

Резистентность микроорганизмов • Приобретенная устойчивость развивается либо вследствие мутаций, либо при передаче генов, кодирующих резистентность, от резистентных бактерий чувствительным микроорганизмам. • Мутационная резистентность возникает спонтанно у отдельных представителей популяции бактериальных клеток. • В отсутствие антибиотиков резистентные мутанты, как правило, не имеют преимуществ перед чувствительными бактериями в борьбе за существование.

Резистентность микроорганизмов • Различают 4 основных механизма, опосредующих приобретенную устойчивость к антибиотикам: - деструкция (разрушение) или инактивация (модификация) антибиотика; - изменение мишени действия антибиотика; - уменьшение проницаемости клеточной стенки, блокада механизмов транспортировки антибиотика внутрь бактериальной клетки, либо активное выведение медикаментов из микроорганизмов; - приобретение нового метаболического пути взамен того, который подавляется антибиотиком.

Резистентность микроорганизмов • С клинической точки зрения, наиболее важным из них является способность микроорганизмов синтезировать ферменты, разрушающие антибиотики. Бактериальные ферменты, разрушающие b-лактамные антибиотики, получили название b-лактамаз.

Резистентность микроорганизмов • Еще один механизм резистентности — приобретение бактериями способности активно удалять (выкачивать) антибиотики из клеток с помощью насосов. Так, этот механизм характерен для приобретенной устойчивости к тетрациклинам. Антибиотики, проникшие внутрь бактерии, изгоняются из нее наружу. В результате они не успевают связаться со своими мишенями (если речь идет о тетрациклинах, то с рибосомами) и оказать антибактериальное действие.

Резистентность микроорганизмов • Следующий механизм резистентности — нарушение проницаемости бактерий для антибиотиков. Пенициллинсвязывающие белки — мишени для действия b-лактамных антибиотиков — у грамположительных микроорганизмов не прикрываются никакими защитными барьерами. Напротив, у грамотрицательных бактерий эти белки прикрыты наружной фосфолипидной мембраной. bлактамы проникают через этот защитный барьер посредством диффузии через поры, которые образуются “пуриновыми” белками. Уменьшение числа или радиуса пор сопровождается снижением чувствительности бактерий к антибиотикам.

РАЦИОНАЛЬНАЯ АНТИБИОТКОТЕРАПИЯ

При назначении антибиотикотерапии ветеринарному врачу необходимо предварительно ответить самому себе на следующие вопросы: • • Есть ли клинические показания для назначения антибиотиков? Взят ли материал для бактериологического посева? Какой наиболее вероятный возбудитель заболевания? Какие особенности пациента необходимо учитывать? Какой наилучший путь введения? Какая доза и кратность введения? Предполагаемая длительность лечения? Какой из доступных антибиотиков является наилучшим для данного пациента?

Основные правила антибактериальной терапии 1. Установить возбудителя заболевания. 2. Определить препараты, к которым возбудитель наиболее чувствителен. 3. При неизвестном возбудителе использовать либо препарат с широким спектром действия, либо комбинацию двух препаратов, суммарный спектр которых включает вероятных возбудителей. 4. Начинать лечение надо как можно раньше. 5. Выбор антибиотика, его дозы и способа введения должны исключить или существенно уменьшить повреждающее действие препарата на макроорганизм.

Основные правила антибактериальной терапии 6. Продолжительность лечения должна быть достаточной для элиминации возбудителя из организма; снижение температуры тела и ослабление других симптомов не являются основанием для прекращения лечения. Препарат нужно назначить в такой дозе (разовой и суточной) и так вводить, чтобы обеспечить его среднюю терапевтическую концентрацию в тканях и жидкостях макроорганизма на протяжении всего курса терапии. 7. Должен быть выбран рациональный путь введения препаратов, учитывая, что некоторые из них не полностью всасываются из желудочно-кишечного тракта, плохо проникают из крови в мозг (через гематоэнцефалический барьер). 8. Комбинированное применение антибактериальных средств должно быть обоснованным, так как при неправильном сочетании может как ослабляться суммарная активность, так и суммироваться их токсические эффекты.

«Успешность» действия антибиотиков определяется следующими факторами: • дозированной лекарственной формой, обеспечивающей соответствующую фармацевтическую доступность лекарственного вещества; • количеством антибиотика, т. е. дозой; • целостностью его в тканях, органе (в очаге инфекции), что обусловлено скоростью его метаболизма и/или элиминации.


Степень чувствительности микроорганизмов • По степени чувствительности к основным антибиотикам микроорганизмы подразделяются на чувствительные, умеренно чувствительные и устойчивые. • В группу чувствительных входит большинство штаммов микроорганизмов, рост которых на питательных средах прекращается при использовании концентраций, соответствующих средним терапевтическим дозам антибиотиков. • Если рост микроорганизмов угнетается применении только максимальных доз препаратов, то такие микроорганизмы умеренно чувствительны к антибиотику. • Если подавление роста достигается в опыте in vitro, при очень высоких концентрациях препарата, которые нельзя создать в организме, то такие возбудители инфекции относятся к устойчивым к антибиотику.



Предварительный диагноз ставят: • на основании эпизоотологических, клинических и патологоанатомических данных, а окончательный — по результатам бактериологического, серологического и других необходимых методов исследования. Материал для лабораторных исследований следует брать до начала проведения антимикробной терапии, так как после применения этих препаратов могут измениться морфологические особенности и культуральные свойства возбудителя, иммунологическая реактивность макроорганизма, что затруднит постановку диагноза.

• После постановки окончательного диагноза следует решить вопрос о целесообразности назначения другого препарата, в первую очередь узкого спектра действия, к которому наиболее чувствителен возбудитель данного заболевания.

• Антибактериальные препараты следует применять животным в течение определенного периода времени (курса лечения), необходимого для полного подавления инфекции и клинического их выздоровления, а в некоторых случаях, при рецидивирующих инфекциях, — по возможности до полной санации организма. • Продолжительность лечения колеблется в зависимости от течения и тяжести заболевания и заранее не может быть строго регламентирована • При острых инфекциях антимикробные препараты обычно назначают в течение 3 -7 дн. ; если клинический эффект не наблюдается через 3 - 4 дня после начала лечения, то следует перейти к терапии другими препаратами; при хронических инфекциях - до 15 -30 дней.

Профилактическое применение антибиотиков целесообразно при реальной угрозе возникновения болезни бактериальной этиологии среди определенных групп животных. При выявлении инфекционного заболевания на ферме массовая обработка всех животных, включая клинически больных, а также подозреваемых в заражении, дает возможность прервать инфекционный цикл и добиться излечения всего поголовья.

Нерациональное применение антимикробных средств: • введение недостаточных (субтерапевтических) доз, • увеличение интервалов между введением препарата, • необоснованное увеличение длительности курса лечения, не только снижает терапевтическую эффективность антимикробных препаратов, но и способствует возникновению резистентных штаммов патогенных микроорганизмов.

Резистентность • Под резистентностью микроорганизмов к антибиотикам понимают сохранение их способности к размножению в присутствии таких концентраций антибиотиков, которые создаются при введении терапевтических доз.

Скорость развития лекарственной устойчивости к антимикробным препаратам у микроорганизмов Медленно Постепенно Быстро Амфотерицин Б Леворин Нистатин Гризеофульвин Фурацилин Фурадонин Фуразолидон Фурагин Фторхинолоны Соли бензилпенициллина Феноксиметилпенициллин Бициллины Оксациллин Ампициллин Карбенициллин Цефалоридин Цефалексин Неомицин Канамицин Гентамицин Апрамицин Тетрациклин Окситетрациклин Хлортетрациклин Доксициклин Левомицетин Полимиксин Сульфаниламиды Стрептомицин Эритромицин Олеандомицин Линкомицин Фузидин Рифампицин

Предупреждение развития резистентности • Учитывая, что патогенные микроорганизмы обладают высокими адаптационными способностями, в целях борьбы с появлением устойчивых штаммов не следует применять в одном и том же хозяйстве один и тот же антибиотик длительное время. • При появлении устойчивости микробов к одному антибиотику следует перейти к применению других антимикробных препаратов.

Два пути преодоления антибиотикорезистентности • Создание новой оригинальной молекулы антибиотика, к которой у микроорганизмов еще не выработалось механизмов резистентности. • Применение комплексных препаратов, содержащих два антибиотика, каждый из которых имеет свой механизм действия в отношении микроорганизма

Комплексная антибиотикотерапия • • ПРЕИМУЩЕСТВА!!! Максимальное расширение спектра антимикробного действия при тяжелом течении инфекции, требующем немедленного начала лечения до установления бактериологического диагноза, или при смешанной инфекции, когда возбудители микробной ассоциации имеют разную чувствительность к антибактериальным препаратам. Предупреждение развития токсического действия за счет достижения быстрого и более полного эффекта при одновременном введении двух или нескольких препаратов в меньших, чем обычные, курсовых дозах. Возможность усиления антибактериального эффекта в расчете на синергидное взаимодействие антимикробных препаратов. Предупреждение или замедление развития резистентности у микроорганизмов.

Рациональные комбинации антибиотиков. • • 1. Для расширения спектра действия. Пример: Бензилпенициллин с аминогликозидами Пенициллины активны в отношении кокковой микрофлоры, но не активны в отношении грамотицательных микроорганизмов; • Аминогликозиды слабо активны в отношении коковой микрофлоры, но активны в отношении грамотрицательных микроорганизмов. • Комплексное применение этих двух групп антибиотиков приводит к расширению спектра действия на грамположительные и грамотрицательные микроорганизмы.

Рациональные комбинации антибиотиков • 2. Для усиления силы действия – препараты разных групп. • При совместном применении антибиотиков возможно развитие синергидного или аддитивного действия (взаимоусиливающего действия), что позволяет снизить дозу каждого из антибиотиков. • Пример. Пенициллин усиливает действие стрептомицина, за счет того что пенициллин, нарушая целостность клеточной стенки микроорганизма, способствует лучшему проникновению в нее стрептомицина.

Рациональные комбинации антибиотиков • • 3. Для профилактики побочного действия Пример: Тетрациклин+нистатин Тетрациклин вызывает дизбактериоз и суперинфекцию в форме кандидамикоза • Нистатин-противогрибковый антибиотик, тормозит развитие грибковой микрофлоры.

Рациональные комбинации антибиотиков • 4. Для замедление развития резистентности у микроорганизмов. • Пример: • Выращивание эшерихий на питательной среде, содержащей суббактериостатические концентрации хлорамфеникола, через 7 пассажей приводит к появлению антибиотикорезистентных микроорганизмов. • Добавление в питательную среду к хлоамфениколу суббактериостатических концентраций хинозола, даже через 12 пассажей не приводит к появлению антибиотикорезистентных микроорганизмов.

Нерациональные комбинации антибиотиков • Не комбинировать антибиотики с одинаковым побочным действием - усиление токсичности. Пример: - тетрациклин + рифампицин приводит к усилению гепатотоксичности каждого из антибиотиков • Не комбинировать антибиотики с разным характером действия на микроорганизмы Пример: - тетрациклин + пенициллин приводит к ослаблению антимикробного действия за счет разного действия на микроорганизмы, т. к. первый антибиотик обладает бактеристатическим действием (приводит к остановке развития клетки), а второй антибиотик обладает бактерицидным действием и активен только в отношении делящейся клетки.

КАКОЙ АНТИБИОТИК ВЫБРАТЬ ? “В выборе вина я не испытываю трудностей… …меня удовлетворяет самое лучшее” Уинстон Черчилль Нужно стремиться использовать антибиотики с длительным опытом применения и хорошо известным уровнем безопасности.
Lektsia11-_AntibakterPr-ty_ispravl.ppt